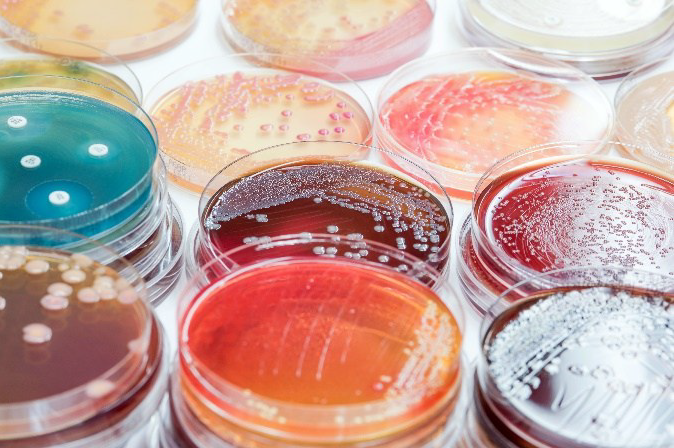

WIR SUCHEN DICH! Bundesfreiwilligendienstler:in für Büro- und Verwaltungsarbeiten
Richte deine Bewerbung an: bewerbung@bildungswerk-clp.de


Cafe International

Generationen Cafe`
Hygienebeauftragte:r
in der Pflege und anderen betreuten gemeinschaftlichen Wohnformen
Demnächst in Cloppenburg
Palliativmedizinische Behandlungsmethoden in schwierigen Situationen
Religiöse Traditionen bei Bewohnern in der Betreuung
Eine Einladung zur Hoffnung
Koordinationstraining für Erwachsene – Life Kinetik
Kräuterkunde – Heimische Wildpflanzen verstehen und wertschätzen
Allgemeiner Integrationskurs ab dem 27.04.2026 900429-NI-89-2026 (Nachmittagskurs)
Excel– Einstieg in die Büropraxis ohne Vorkenntnisse
Bildbearbeitung mit Photoshop Elements inkl. Entwicklung von RAW-Dateien
Anliegen klären-Menschen verstehen
Liebe ist mehr als nur ein Wort Gnadenkapelle St. Marien, Bethen









